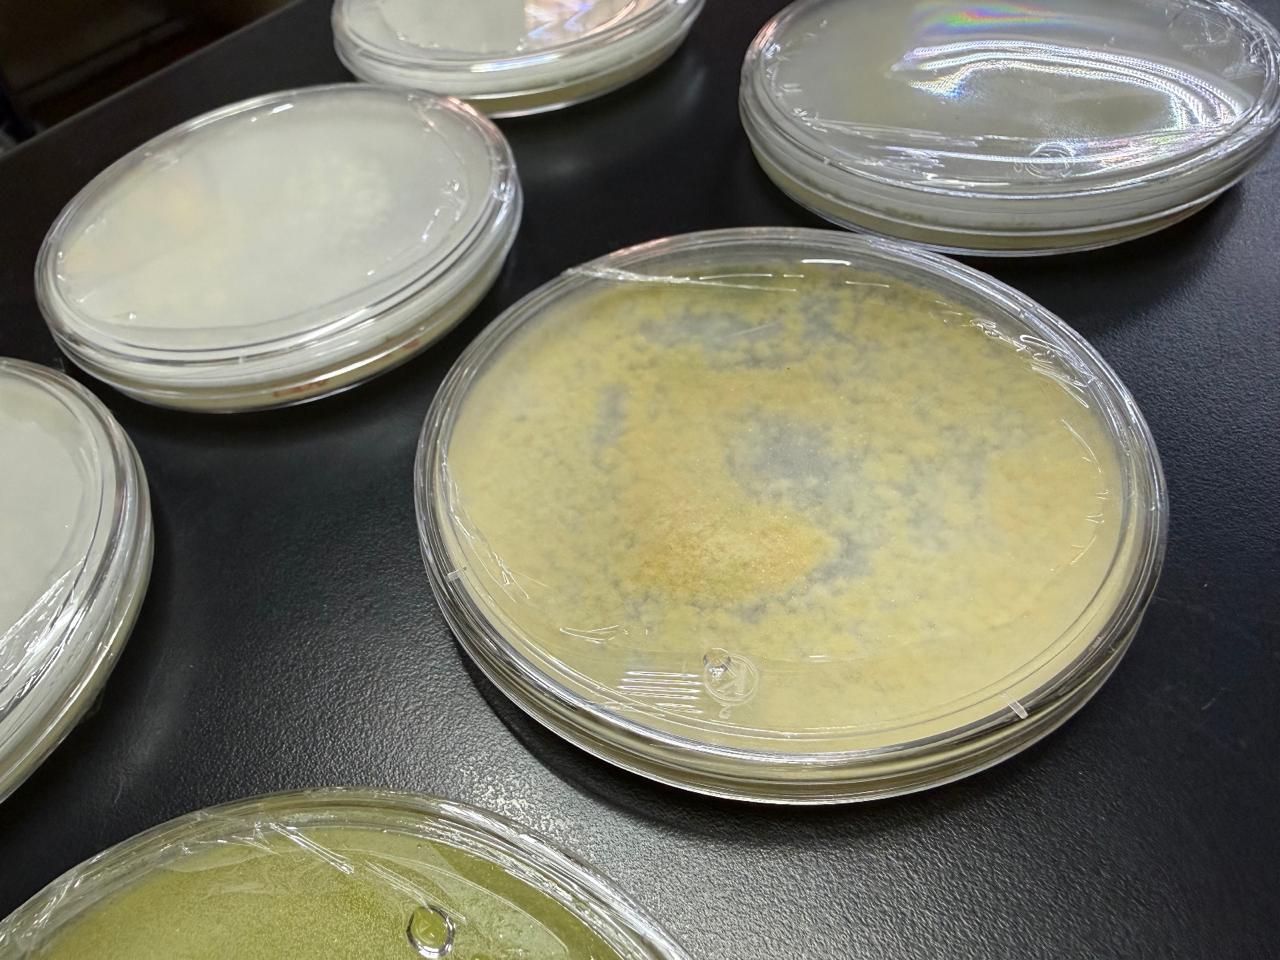
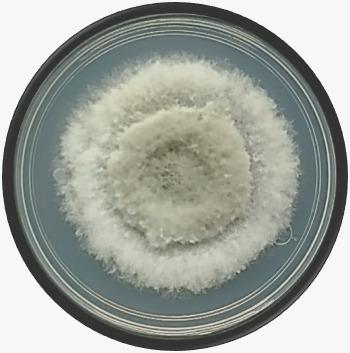

Investigador de la UG estudia hongos para proteger cultivos

Guanajuato, Gto., a 22 de abril de 2026.- Un investigador de la Universidad de Guanajuato desarrolla un estudio sobre hongos que afectan cultivos, con el objetivo de comprender su proceso infeccioso, fortalecer el sistema inmune de las plantas y reducir pérdidas en el sector agrícola.
El proyecto es encabezado por el maestro Axel Gerardo Sánchez Fonseca, del Laboratorio de Interacción Planta Microorganismo, con asesoría de la doctora Vianey Graciela Olmedo Monfil y colaboración de la doctora Diana Sánchez Rangel, del Instituto de Ecología A. C.

La investigación se centra en el análisis de la capacidad patogénica de hongos, es decir, en la forma en que generan enfermedades en sus organismos hospederos. Durante su posgrado, el investigador enfocó su estudio en el hongo Neofusicoccum, el cual afecta plantas leñosas como la vid.
De acuerdo con el estudio, este hongo representa un riesgo para la industria del vino en Guanajuato, ya que la vid es una de las plantas más afectadas. Comprender su mecanismo de infección permitirá proponer alternativas de control para disminuir daños y limitar el uso de pesticidas.
El hongo Neofusicoccum cuenta con registros iniciales en Europa. En México, se identificó en árboles de Liquidámbar en Veracruz, lo que sugiere su introducción mediante material vegetal infectado.
Para su análisis, el investigador realiza la recolección de muestras en madera, hojas, plantas y suelo. Posteriormente, aplica técnicas moleculares y de microbiología para identificar el tipo de hongo y su comportamiento.
El estudio también contempla el trabajo con productores agrícolas, con el fin de conocer problemáticas en campo y generar soluciones con impacto directo en los cultivos.
El objetivo actual de la investigación consiste en fortalecer el sistema inmune de las plantas mediante estrategias que mantengan activas las fitohormonas, elementos clave para su desarrollo y defensa ante infecciones.
El proyecto forma parte de las líneas de investigación impulsadas por la Universidad de Guanajuato en materia de ciencia aplicada, con enfoque en el sector productivo y el desarrollo agrícola.
Leer más: UG patenta tecnología para mecanizar el trasplante de agave

El investigador Axel Gerardo Sánchez Fonseca señaló que su interés por la ciencia ha guiado su formación académica y el desarrollo de su trabajo en la Universidad de Guanajuato, donde ha fortalecido sus conocimientos a través de la colaboración, la capacitación constante y el acompañamiento de especialistas.
“Mi interés por la ciencia ha estado presente siempre, en gran parte por la libertad que brinda para explorar distintos temas”, comentó Axel Sánchez.
Indicó que el trabajo en equipo dentro del Laboratorio de Interacción Planta Microorganismo, así como la asesoría de sus mentoras y mentores, ha sido clave en su trayectoria académica y profesional.
Desde su perspectiva, subrayó la importancia de que más personas se interesen por la investigación científica y la exploración de nuevas líneas de conocimiento con impacto social.
“A las y los estudiantes con interés en esta área, les recomiendo tener inquietud por resolver problemas reales. Es importante contar con bases teóricas sólidas, pero, sobre todo, con creatividad para diseñar estrategias cuando no existen protocolos establecidos. El perfil de quienes aspiran a estos programas educativos debe ser el de personas curiosas y con gran interés por la ciencia, sin temor equivocarse”, finalizó.
La Universidad de Guanajuato informó que la oferta educativa de nivel licenciatura y posgrado puede consultarse en su portal institucional.